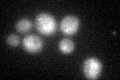
YJR033C
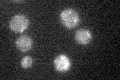
YJR033C

View description
Subunit of the RAVE complex (Rav1p, Rav2p, Skp1p), which promotes assembly of the V-ATPase holoenzyme; required for transport between the early and late endosome/PVC and for localization of TGN membrane proteins; potential Cdc28p substrate
Localization:
Intensity:
Fold change:
Significance:
-
C’ GFP library in SD

below threshold19.57 -
N' NOP1pr-GFP in SD

cytosol106.802 -
N' TEF2pr-mCherry in SD

cytosol70.2437 -
N' NATIVEpr-GFP in SD

punctate23.7528 -
N' TEF2pr-VC and Cyto-VN in SD

cytosol48.4876 -
C’ GFP library in SD+DTT
cytosol24.661.25No -
C’ GFP library in SD+H2O2

cytosol23.181.18No -
C’ GFP library in Starvation Media
cytosol24.911.27No -
C’ GFP library on the background of Pup2-DaMP

below threshold -
C’ GFP library on the background of CCT mutant

below threshold16.66010.850785No
